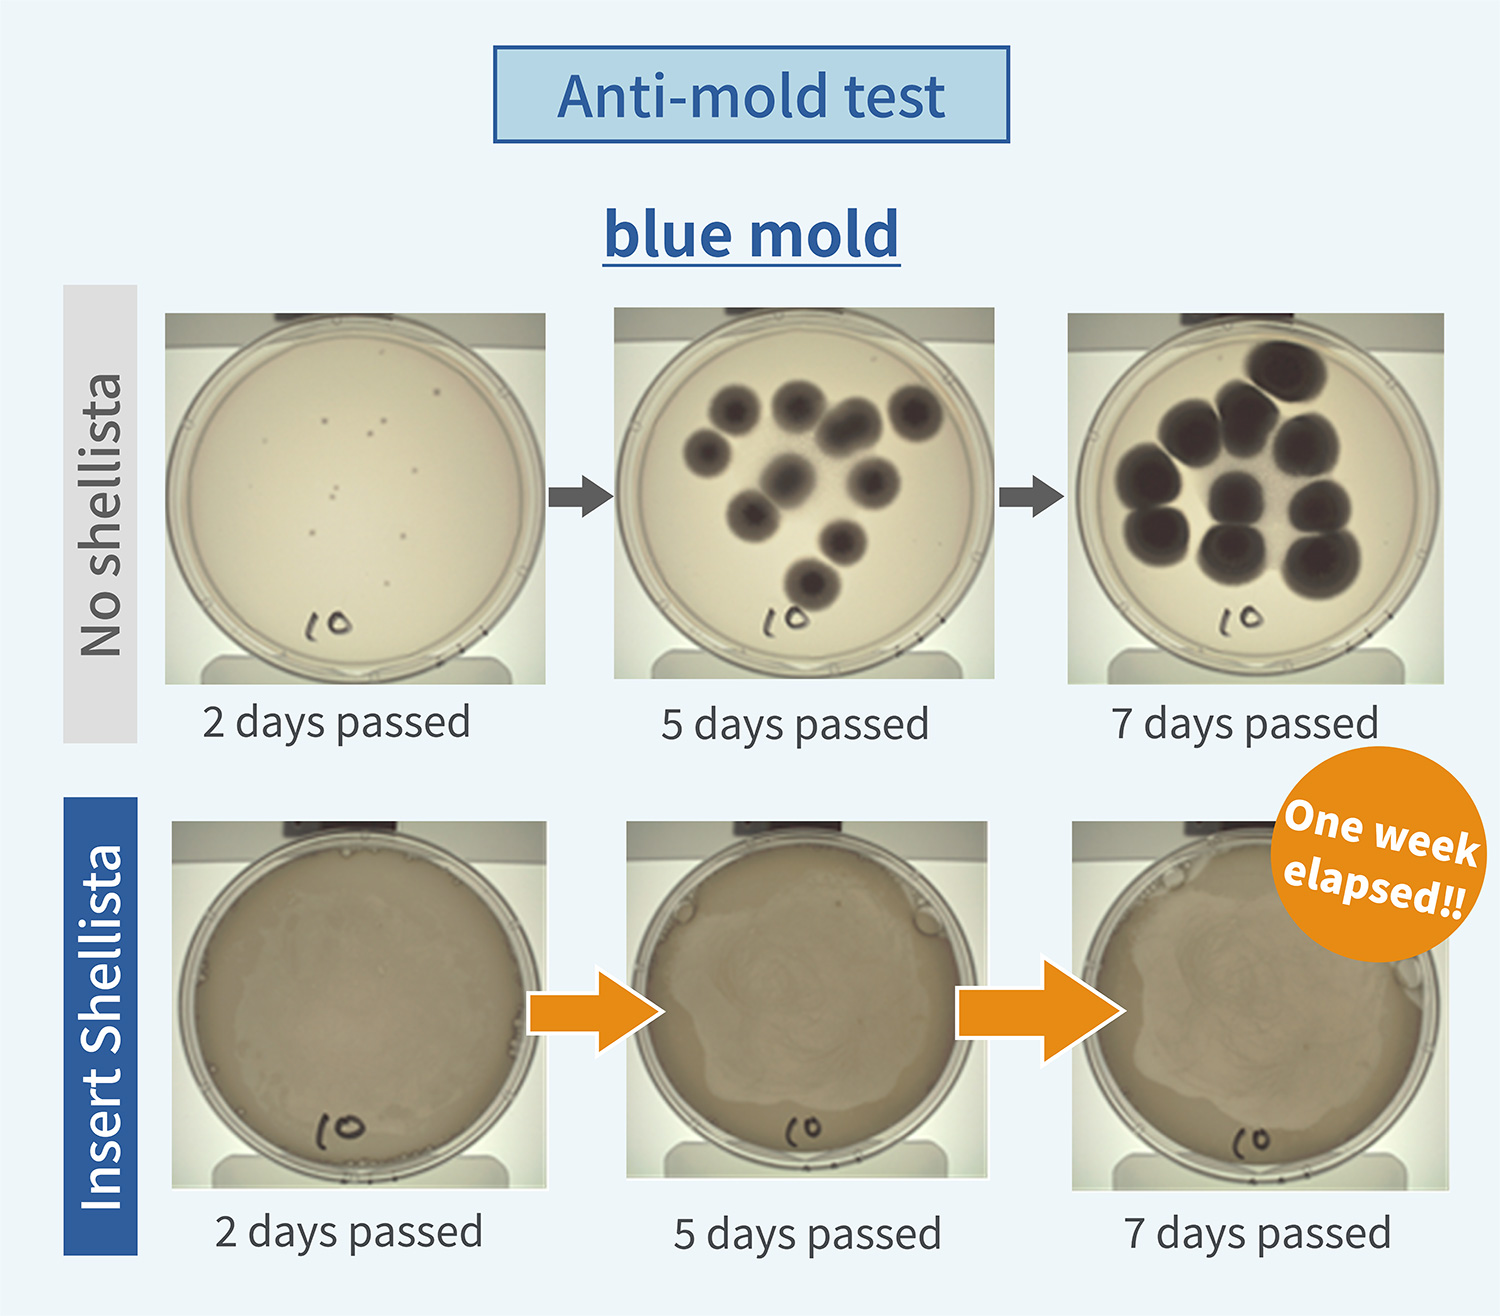
Anti-mold test result1
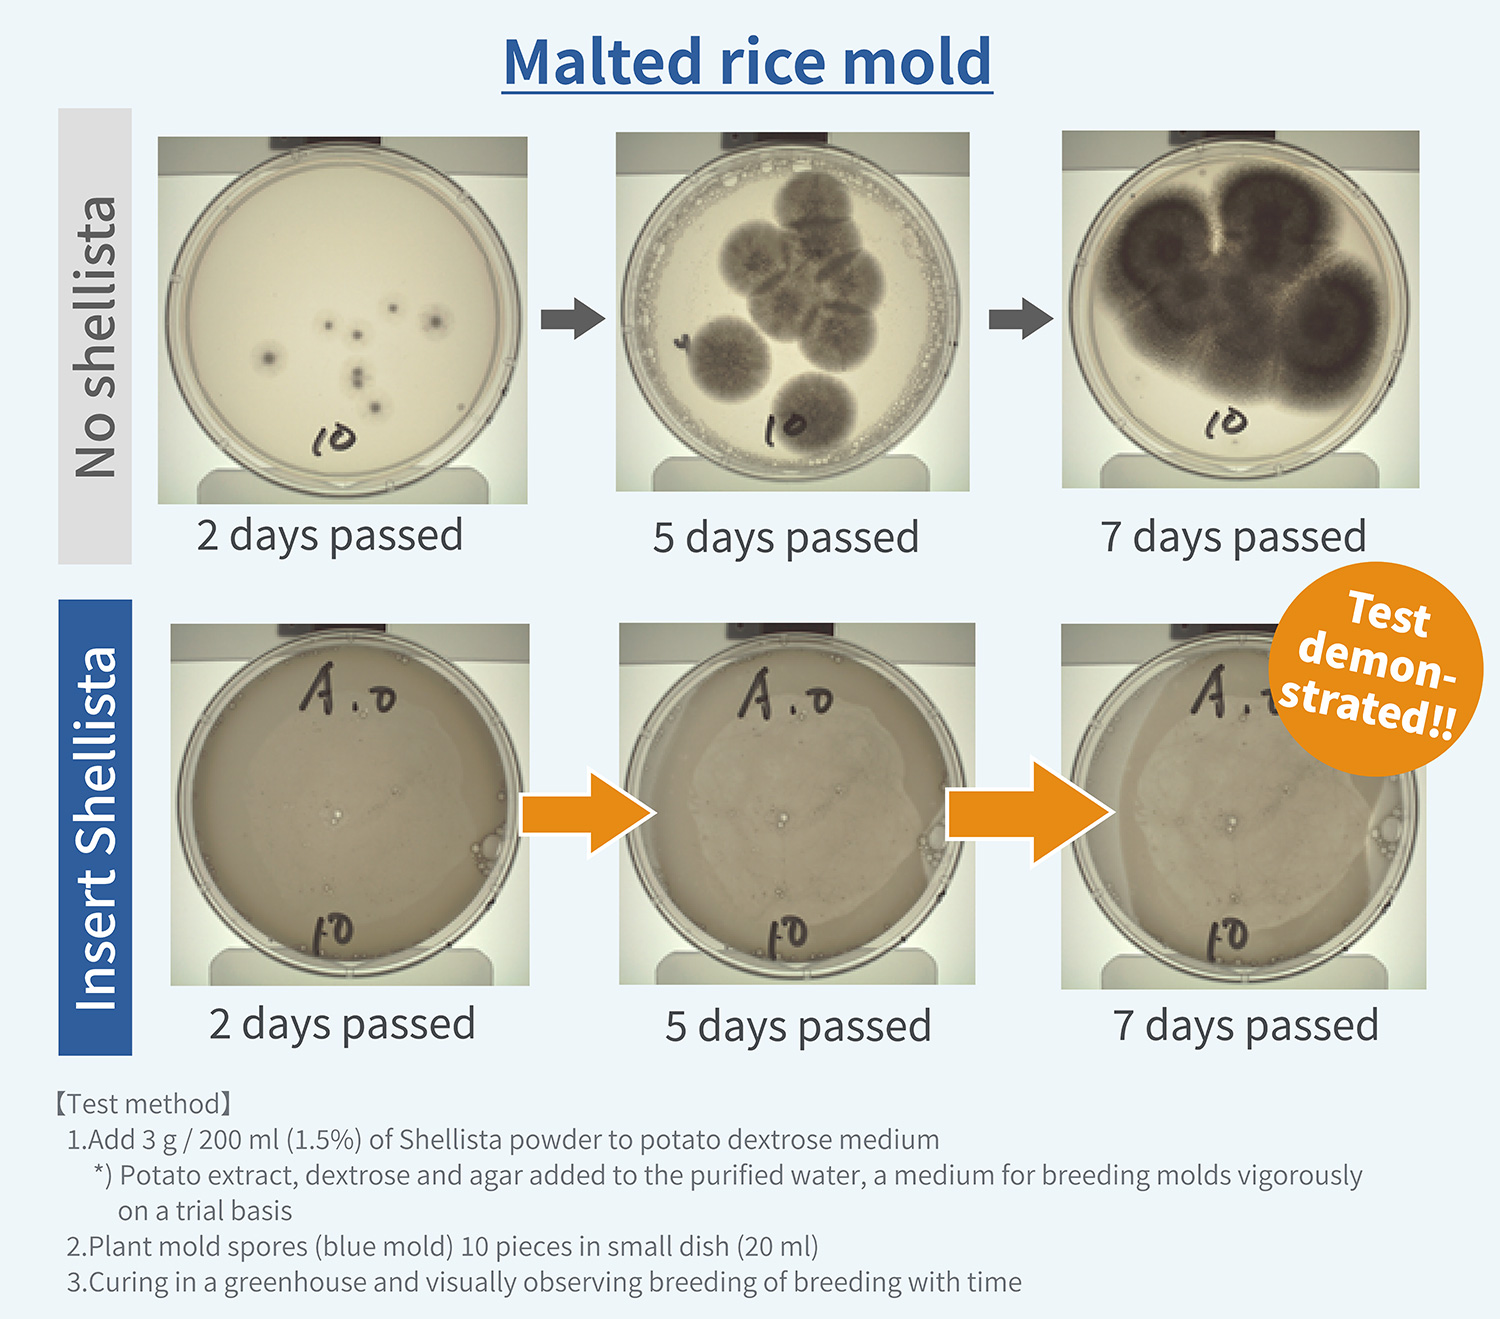
Anti-mold test result2

Shellista sanitisation deodorant spray
Difference with the general sanitisation cleaner and the deodorant spray
Shellista sanitisation deodorant spray processes is made of the scallop shell of Ohotsuku Sea, Hokkaido marine products by the original manufacturing method, and there are sanitisation and deodorization effects by the strong alkaline power which it dissolved in the pure water. It is only made from the natural ingredient and water, it can be use for the kitchen circumference, the refrigerator and the clothes, inside of the car for sanitisation and the deodorization by a wide range of applications with relief.
Do not mix it and it is not in danger

The main ingredient of the general sanitisation cleaner sells at the drugstore or the supermarket is "sodium hypochlorite" used as a chlorine system bleach for family use or a bleach for the pools. This type of product have a distinctive smell with your nose, and there is the risk to have fatal accidents if you mix it with other detergents, then to produce chlorine gas. This is so-called; "do not mix it, and is called danger". Shellista is made from 100% natural ingredient which has non-chemical ingredient so you can use it without thinking about such a serious danger.
Non-alcohol

When you use the alcohol-based sanitisation deodorizer, there are the cases to get the rough skin as it attach to your skin, or the rash might caused, or you might feel sick and may become hard to breathe just to have smell it. The people who has alcohol hypersensitivity or asthma needs to perform the handling of the alcohol sanitisation deodorant water spray carefully. Shellista has non-alcohol ingredient, so you can use it with relief even if you are sensitive to the alcohol.
Get rid of the smell from the original

The deodorant spray spreading widely in Japan is using the masking method by coating the bad smell ingredient with a fragrance. Unlike the deodorant spray to shut the smell with the fragrance, Shellista has no fragrance so it can get rid of a smell from the original by strong alkaline power. Please pay your attention to the place that you can deodorize without any fragrance.
Environmental friendly

Shellista is made from 100% of the natural ingredients, it does not use any synthetic surfactant, preservative, coloring agent, fragrance at all. There is a feature that is usable to the place worried about the smell, the bacteria, or the virus without worrying about the influence on health that being use the spray as it is usable as food additives. In addition, the main ingredient of the scallop shell is washing and sterilizing carefully, so we consider the environment by reusing it. Shellista is an environmental friendly sanitisation deodorant water spray who has babies or small children in the family, or interested in the Eco, the environment load, or the health conscious.
High sanitisation effect for the bacteria and the virus
Various bacteria and viruses decreased by 99.9%
Various bacteria are lurking in our daily life. Especially for babies and elderly people, severe damage from the bacterial infection to the body is considered, so appropriate treatment is required. In the eradication test of Shellista, bacteria soaked in the shellista were eradicated more than 99.9% after 10 minutes, and some results are also shown. Even a natural ingredient can obtain a sanitisation effect firmly.

Effective for the sanitisation of Virus
It is virus to be representative as viral food poisoning. The feature of virus causing the infectious disease gastroenteritis is that it is prevalent mainly in the winter, and an infection power is very high, and it develops for outbreaks in no time at the place performing the communal living including the school and the hospital. Following three are important to prevent infection expansion of virus in the home.
- 1.Clean up the vomit and excreta and feces immediately
- 2.sanitize the outskirts after clean up appropriately
- 3.Wash your hands carefully after clean up
The sanitisation method by 2 is recommended to heat at 85 degrees Celsius more than 1 minute, or to use a sanitisation agent. It is not enough for sanitisation of virus by the reverse soap or the alcohol sterilization. 78.5% of virus decreased in 10 minutes by the sanitisation examination of Shellista.
Strong deodorization effect against the bad smell
There are a lot of places worried about the smell in everyday life. For example, the triangle corner in the sink and the kitchen circumference, the restroom and the shoebox, the refrigerator and the trash box, the pets article, inside of the car. Shellista shows an effect for such a smell. In the deodorant examination, the strong irritating odor such as "the smell of egg which became addled", "ammonia" or "steamed socks" were decreased 99.9% after 10 minutes using by Shellista.

High anti-mold effect
In the examination that measured for anti-mold effect of Shellista, the representative mold bacteria such as blue mold, Koji mold, and Black Koji mold got the result that could restrain breeding of the mold even 7 days later in comparison with time when we did not use Shellista. Shellista is very effective for the bathroom and the kitchen when it becomes the rainy season and the summer as the indoor environment of high temperature and humidity.

Usable for the various places
Shellista can use for the various places in the everyday life such as washing and sanitisation of the vegetables and the fruits, sanitisation of the kitchen and the restroom, the baby article and the pet article, the bathroom and the washing machine, the car and the sofa, and the bed including deodorization and sanitisation. Shellista is effective to the things which cannot easily wash like the plush dolls and the toys, the sofa and the car seat.
The toys and the plush dolls of the children

It is recommended to sanitize the toys routinely because the baby often put the toys in a mouth.
Sofa and bed

It does not use any chemical ingredients and alcohols at all, you can use with relief for a person who is mind to the influence on the body.
Clothing, shoes and socks

For clothing and shoes which you cannot to wash readily and is worried about a smell.
The car seat and the floor mat

The food waste and dirts on the floor mat in the car, the car seat with sweat infiltrated and the smell in the car.
FAQs
-
Q How long does the effect of deodorization and the sanitisation begin to appear from?
-
A The sanitisation and deodorization effect appears in about 10 minutes. This may be inferior to a general organochlorine-based deodorant and alcohol-based sanitisation which is quick effect, but you can feel the merit of 100% natural ingredient being the durability for sanitisation and deodorization effect. It may be easy to understand that if you do have the image that an effect gradually follows for a long time.
-
Q What kind of bacteria can you sanitize?
-
A We do not conduct eradication tests etc. on all pesticides and bacteria / virus, but results that almost no bacteria and viruses are detected have come out.
-
Q Is it alright even if spray it on any place?
-
A It is made of the natural ingredient, so you can use it anywhere. Please spray it on the place you worried about the outbreak of a smell and bacteria. Please refrain from to use it for [the aluminum products and the copper products] as there is a case to be a change of color or a corrode.
-
Q Can you spray to the fabric articles such as clothing?
-
A Yes, you can spray as it is made with the natural ingredient. Please refrain from to use it for [the leather products] as there might be a stain or a shrinkage.
-
Q A smell to come on a nose mincingly is a weak point, is this unscented?
-
A Yes, Shellista is unscented. We recommend it to the people who is weak in the chemical smell among the general sanitisation water spray.
sanitisation deodorant spray
sanitisation deodorant water spray is made from 100% of the natural material which processed the scallop shell of Okhotsuku, Hokkaido marine products by the original manufacturing method.
Ingredient: Pure water, Shellfired calcium
Internal capacity: 300ml
Country of origin: Japan
Price: 1,320yen (tax-included)
How to use
Please spray this product 20-30cm apart as the whole moistens for the place to be worried about the smell and the bacteria.
Use applications
[sanitisation / Washing]
sanitisation and washing of the knife and the cutting board / sanitisation of the drain and take away the slime / sanitisation of the soda and the bed / sanitisation of the stuffed toys and the babies's articles / sanitisation of the car seat and the floor mat
[Deodorization]
Deodorization of the kitchen and the restroom / Deodorization of the raw trash / Deodorization of the shoes box / Deodorization of the diaper / Deodorization of inside of the refrigerator / Deodorization of the pets's articles / Deodorization of the cigarette / Deodorization of the shoes, clothes and socks
Usage notes
- Please do not use it apart from the applications.
- Please do not mix it with other sanitisation agents and the cleaners.
- When it attach to your eyes and mucous membrane by mistake, please wash it away with the water and please receive the diagnosis of the doctor.
- When you drink it by mistake, please gargle immediately and drink 2-3 cups of the water, and please go and see a doctor.
- Please keep it to a shaded cool place and out of reach of an infant.
- Please refrain from to use for the aluminum products and the copper products as this product is alkaline.
- Please warn the leather products as it might be a discoloration and the change of color.
- Please read the notes and the instruction manual of the products before use.
- We may change the design, the specifications without a notice for the quality improvement and the improvement of the product. Thank you for your understanding beforehand.
